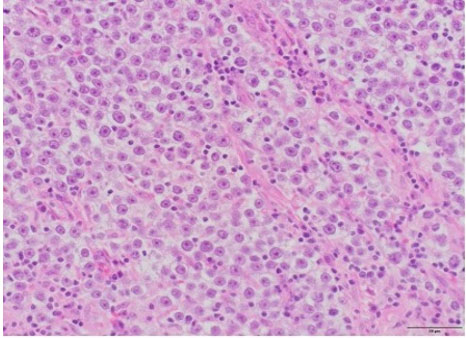

|
Case Series
Incidental discovery of seminoma after simple orchiectomy in transgender individuals: A case series
1 BA, BS, Medical Student, University of Utah School of Medicine, Salt Lake City, Utah, USA
2 MD, Fellow, Department of Urology, University of Utah, Salt Lake City, Utah, USA
3 MD, Assistant Professor of Pathology, Department of Pathology, University of Utah, Salt Lake City, Utah, USA
4 MD, Associate Professor of Plastic Surgery, Department of Plastic Surgery, University of Utah, Salt Lake City, Utah, USA
5 MD, MS, FECSM, Associate Professor of Urology, Department of Urology, University of Utah, Salt Lake City, Utah, USA
6 MD, Assistant Professor, Department of Urology, University of Utah, Salt Lake City, Utah, USA
Address correspondence to:
Telisha Tausinga
BA, BS, University of Utah School of Medicine, 30 N 1900 E, Salt Lake City, UT 84132,
USA
Message to Corresponding Author
Article ID: 100038Z15TT2023
Access full text article on other devices

Access PDF of article on other devices

How to cite this article
Tausinga T, Snyder L, Mahlow J, Agarwal C, Hotaling JM, McCormick BJ. Incidental discovery of seminoma after simple orchiectomy in transgender individuals: A case series. J Case Rep Images Urol 2023;8(2):22–29.ABSTRACT
Introduction: Seminoma is a common malignancy reported in young, cisgender men. However, there is sparse literature describing cases of seminoma in the transgender and gender diverse patient population.
Case Series: We present two cases of seminoma incidentally discovered after simple bilateral orchiectomy performed as part of genital gender affirming surgery. In both instances, patients had not reported any testicular firmness or abnormality prior to surgery. After a thorough literature review, only two other such cases have been reported. Herein, we discuss our two cases and their implications for surgical management of suspected testicular malignancy intraoperatively, a methodical inspection of testicles removed during gender affirming surgery and providing affirming care when navigating discussions of genitalia with transgender and gender diverse patients.
Conclusion: Testicular malignancy such as seminoma may be found incidentally when transgender and gender diverse patients undergo genital gender affirming surgery. Thus, special attention is required to identify suspicious exam findings, adjust surgical techniques as indicated, and properly examine surgical specimens. As there is a significant paucity of literature surrounding testicular malignancies in the transgender and gender diverse patient population, it is crucial to continue to investigate how to provide affirming care in these situations.
Keywords: Gender-affirming surgery, Seminoma, Surgical pathology inspection, Transgender health
Introduction
Gender affirming surgery (GAS) is becoming increasingly utilized for the treatment of gender dysphoria. The World Professional Association for Transgender Health (WPATH) sets forth specific standards of care for GAS and other affirming care, such as gender affirming hormonal treatment (GAHT). Gender affirming surgery has been repeatedly shown to be safe and effective, ultimately improving the quality of life and well-being of transgender and gender diverse (TGD) individuals [1].
For transfeminine patients, genital gender affirming surgery (gGAS), or “bottom surgery,” often consists of a combination of bilateral simple orchiectomy, scrotectomy, vulvoplasty, vaginoplasty, and labiaplasty performed by a multidisciplinary surgical team [2],[3]. At times simple orchiectomy is performed on its own with or without a plan for additional procedures in the future.
The surgical approach for simple orchiectomy in these cases depends on the patient’s transition goals. For individuals undergoing simple orchiectomy with plans for vaginoplasty in the future, orchiectomy via a single midline scrotal incision with preservation of scrotal skin for future vaginal canal lining can be performed. However, some patients choose to undergo concurrent partial or complete scrotectomy at the time of orchiectomy, either due to the nature of their gender dysphoria or plans that do not require the scrotal skin for future vaginal canal construction, such as vulvoplasty. For patients undergoing vaginoplasty who have not had prior orchiectomy, the orchiectomy and scrotectomy are typically performed concurrently with the vaginoplasty. In these cases, the scrotal skin is removed and used as a skin graft to line the vaginal canal before the testes are dissected and removed. For all approaches, the removal of the testes includes removal of the spermatic cord in its entirety to the level of the external inguinal ring. After the orchiectomy, routine pathological examination of surgical specimens is performed.
Herein we present two cases of transgender women discovered to have testicular neoplasms at the time of gGAS. We discuss their clinical courses and review the current literature surrounding incidental findings of testicular malignancy in TGD patients undergoing gGAS.
CASE SERIES
Two patients undergoing gGAS were identified, a 29-year-old transgender woman presenting for vaginoplasty, and a 32-year-old transgender woman presenting for simple orchiectomy. Each patient met WPATH Standards of Care (SOC) 7 criteria prior to surgery [1] and had variable pre-operative exposures to hormone treatment (Table 1).
Case 1
A 29-year-old transgender woman presented to urology clinic interested in pursuing gGAS. She was evaluated and scheduled for orchiectomy followed by vaginoplasty. Prior to surgery, the patient had a GAHT regimen consisting of bicalutamide, progesterone, and finasteride for over two years and estradiol for over four years. She had a medical history of gender dysphoria, depression with anxiety, chronic constipation, and recent diagnoses of panic disorder and attention-deficit hyperactivity disorder. She had no prior surgeries and no known medical allergies. Of note, she had no history of undescended testicles, orchiopexy, or a family history of cancer.
Intraoperatively, it was noted that the left testis felt atypically firm. Due to the planned removal of the scrotal skin for graft preparation prior to removal of the testis, the surgical team determined that simple orchiectomy via a scrotal approach did not carry a significant risk of potential tumor seeding. Therefore, it was decided that radical inguinal orchiectomy was not indicated. The scrotal skin was elevated and excised in a typical fashion in preparation for vaginoplasty. After a 12 × 24 cm portion of the scrotal skin was removed, simple orchiectomy was performed. Both testicles were dissected free from the cremasteric muscle with the cords stripped to the inguinal canal. On the left side, care was taken to ligate the spermatic cord as close to the internal inguinal ring as possible, being careful to not violate the tunica vaginalis. A 3 cm silk tie was left on the cord stump to aid in spermatic cord remnant identification in case of future surgery, such as retroperitoneal lymph node dissection (RPLND). Testicular tumor markers were collected intraoperatively, and specimens were sent to pathology for inspection. Subsequent vaginoplasty was performed the same day without complication.
Surgical pathology revealed a 3.0 × 3.0 × 2.2 cm soft, pale-tan lobulated mass within the left testis (Figure 1). Histology demonstrated pure seminoma with concomitant Leydig cell hyperplasia and no other non-seminomatous germ cell components (Figure 2). The seminoma displayed the classic morphology of epithelioid tumor cells with clear cytoplasm, boxed-off nuclei, and fibrous bands with associated lymphocytes (Figure 3). Immunohistochemistry was not required for the diagnosis. Initial tumor markers (beta-HCG, LDH, and AFP) were normal.
The patient was seen for a routine postoperative visit where repeat tumor markers were drawn, and the diagnosis of testicular cancer was discussed in detail. She will be following up with urologic oncology for surveillance. Otherwise, she had no postoperative complications and is healing well. When asked about specific symptoms of concern leading up to her gGAS, the patient reported that she had once noticed a feeling of firmness in the left testicle months before surgery. However, as the testicle would soon be removed, the patient did not think to mention this feeling of firmness to her physician. During her preoperative genital exam, no abnormalities were noted—thus, the surgical team acted promptly once firmness was discovered on the day of surgery.
Case 2
A 32-year-old transgender woman presented to a urology clinic interested in pursuing gender affirming bilateral simple orchiectomy. She was not interested in more extensive surgery such as vaginoplasty at the time of presentation. Prior to surgery, the patient had a GAHT regimen consisting of bicalutamide, progesterone, and estradiol for over three years. She had a medical history of gender dysphoria and a surgical history of tonsillectomy at age six with no complications. Of note, she had no history of undescended testicles, orchiopexy, or a family history of cancer.
A simple bilateral orchiectomy was performed via a scrotal approach without complication, and the specimens were sent to pathology per routine protocol. Histology identified a subtle, 1.0 cm seminoma with intertubular growth (Figure 4) and associated germ cell neoplasia in situ (GCNIS). Given the atypical growth pattern, the morphologic impression was confirmed with OCT3/4 immunohistochemical stain, demonstrating strong staining in both seminoma and GCNIS (Figure 5). Grossly, the specimens were unremarkable.
The patient was informed of her diagnosis postoperatively and followed up with urologic oncology, where tumor markers were collected and were within normal limits. Axial imaging of the chest, abdomen, and pelvis revealed several indeterminate, solid left lung nodules measuring up to 3 mm and a suspicious hypodensity in the liver. Repeat imaging was reassuring, and the patient continues to follow up with urology for surveillance.
Discussion
This study reports two cases describing incidental findings of seminoma during gGAS. From 2019 to 2022, our surgical team has performed 233 gender affirming orchiectomies for TGD patients, with the two above-reported cases of malignancy—the first, a classical seminoma, and the second, a rare case of intertubular/interstitial seminoma.
Seminoma presentation and classification
Seminoma is the most common malignancy in patients with testes ages 15–34 years old, with an incidence of 5 per 100,000 reported in the general population. Seminoma is a subtype of germ cell tumor (GCT) caused by malignant transformation of primordial germ cells originating from the seminiferous tubercles. Mixed GCTs, clinically referred to as non-seminomatous GCTs (NSGCTs), are typically much more aggressive and may involve retroperitoneal lymph nodes or other extra-gonadal sites.
Patients commonly present after discovering firmness, swelling, or nodularity in their testis or scrotum. Less commonly, seminoma may present with non-classical symptoms related to metastasis such as feelings of heaviness in their pelvis, back pain, cough, or even neurological symptoms, which might represent retroperitoneal lymph node, lung, or central nervous system (CNS) involvement [4],[5].
Pure seminomas respond extremely favorably to platinum-based chemotherapies and have one of the highest cure rates among all carcinoma, with five-year survival rates of over 95% for local and regional diseases. For local stage I seminoma, orchiectomy itself is curative [4]. Higher staged pure seminoma and NSGCTs may require more intensive therapy, combining radical orchiectomy with retroperitoneal lymph node dissection (RPLND), chemotherapy, and radiotherapy [4],[6],[7]. Thus, if a testicular abnormality is suspected intraoperatively, there are many implications surrounding the choice of surgical technique and prompt histological classification to best inform medical and surgical treatment.
Risk factors for seminoma
There are certain factors that increase the risk of developing seminoma, most notably a history of cryptorchidism, which can increase GCT development in the testicle four to six times beyond baseline [4],[7]. Other risk factors include delayed testicular descent, history of orchiopexy, first-degree relatives with a GCT history, and certain environmental factors including chemical compounds such as organochlorines or tobacco use [4],[7]. There is a paucity of literature surrounding testicular neoplasms in transgender women; however, there are some proposed risks of developing seminoma specifically for TGD individuals, including genital tucking and GAHT.
Genital tucking
Genital tucking is a practice utilized by some TGD individuals where the penis and scrotum are placed between the thighs in the perineal area, and the testicles are placed into the inguinal canals. Compression undergarments or tape can be used to keep the genitals in place, resulting in a more contoured genital area [8]. Though research surrounding genital tucking and its effects are limited, one study showed up to of 70% of transfeminine individuals who endorsed tucking had reported side effects including testicular and penile pain, rashes, and itching [9],[10]. The long-term risks of genital tucking for TGD patients, however, are not well described. A theoretical risk of testicular thermal dysregulation, such as in cryptorchidism, leading to increased malignancy has been proposed, though no research has been performed. Of note, both patients described above did not practice tucking prior to surgery.
Gender affirming hormone treatment (GAHT)
There have been studies correlating prenatal and occupational estrogen exposure as a risk factor for germ cell tumor development, both in animal models and in epidemiological investigations [4],[7],[11],[12],[13]. However, it is less clear how exposure to estrogen as a part of GAHT specifically impacts the risk for developing testicular malignancy. Prior retrospective reviews observed features of GAHT in testicular tissue obtained after gender-affirming orchiectomy. Pathologic analysis revealed decrease in volume, tubular atrophy within peritubular fibrosis, maturation arrest, Sertoli-only tubules and, in a rare subset of cases, no identifiable pathologic changes [14],[15],[16]. There are also two larger population-based reports in the United States and Netherlands investigating the testicular cancer incidence in TGD individuals with varied conclusions. The first study used the North American Association of Central Cancer Registries database and showed an elevated proportional incidence ratio for TGD individuals with diagnoses of viral infection-induced cancers as opposed to male or female individuals. However, the study was limited by database classifications of gender and lack of data on GHAT or gGAS [17]. The second was a cohort study in the Netherlands which included over 3000 transgender women and showed no difference in rates of testicular cancer in transgender women compared to cisgender men. They identified three cases of testicular malignancy, one discovered incidentally after undergoing orchiectomy and two where patients presented with a painless scrotal mass [18]. Of note, this study’s rate of malignancy is nearly 10 times lower than that of our institution’s observed rate of 2 per 223 cases which prompted this research investigation.
Ultimately, more investigation is needed to characterize the impact of GHAT on testicular malignancy and the considerations providers should take when counseling TGD patients on beginning GHAT.
Testicular neoplasms in transgender women reported in literature
At the time of writing, five case reports were identified detailing testicular malignancy discovered in TGD individuals presenting for gGAS or other gender-affirming treatment.
Only four reports involve the incidental discovery of testicular malignancy at the time of surgical pathologic inspection—our two cases described above, one case identified during a national cohort study [18], and the first described by Kvach and colleagues. In this first reported case, a 30-year-old transgender woman presented for a penile inversion vaginoplasty and was found to have a 2.1 cm seminoma of the right testicle upon routine surgical pathologic inspection. Of note, her preoperative genital exam was within normal limits, outside of the presence of atrophic testicles, an expected finding after two years of GHAT [19].
Two reports describe transgender women presenting with a specific genitalia concern. In one instance, a transgender woman presented to her provider with scrotal discomfort. She was found to have a 2.5 cm mass on left testicular ultrasound which prompted an expedited radical orchiectomy. Surgical pathology identified a mixed germ cell tumor [20]. Another case describes a 30-year-old transgender woman who presented with a painless mass in her right scrotum confirmed on exam. A full medical workup ensued and was notable for a CT scan showing a lobulated tumor concerning for malignancy. She underwent radical right orchiectomy, and pathologic inspection confirmed the diagnosis of mature teratoma [21].
Lastly, two cases describe transgender women presenting with concerns surrounding increasingly masculine features while on GHAT. A 31-year-old transgender woman presented with complaints of persistent masculine features despite GAHT adherence. Though she had a normal genital exam on presentation, an elevated serum β-hCG prompted testicular ultrasound. Results were concerning for malignancy, and she underwent a right radical orchiectomy with pathology confirming a pure seminoma [22]. Another case reviews a 28-year-old transgender woman who presented with the complaint of erections while on GHAT. A tender left testicle was discovered on exam, with ultrasound findings concerning malignancy. The patient underwent left radical orchiectomy with pathology confirming testicular NSGCT with embryonal carcinoma, and ultimately underwent contralateral orchiectomy and RPLND. Of note, the patient stated that she avoided touching her testicles and had attributed the tenderness to normal changes on GHAT, which is why she did not mention this to her provider [23].
Though literature is limited, these case reports provide specific scenarios TGD individuals may present for care. In addition to our case series, these reports underline the importance of a thorough history, physical exam, and inspection of surgical tissue after orchiectomy, as a physical exam may not also indicate any testicular concern.
Implications surrounding methodical pathological inspection during gGAS
As described earlier, we identified a classical pure seminoma and a rare case of intertubular/interstitial pure seminoma. There is no difference clinically or biologically other than intertubular/interstitial pure seminoma is grossly normal and easily missed on both gross and histologic exam under the microscope. In the case of the above-described intertubular/interstitial seminoma, a methodical pathologic examination was crucial to secure the diagnosis, as the testicles were grossly normal. This underscores the importance of routine pathological inspection during gGAS, though the additional cost of pathology may be a barrier for patients pursuing self-pay gGAS.
Additional considerations when treating TGD patients undergoing gGAS
Many TGD patients undergoing gGAS have anatomical dysphoria, where their genitals are not consistent with their gender identity [1]. This non-congruence may contribute to patients’ hesitance to discuss genital concerns with their surgeons or avoidance of self-genital exams. Therefore, it is prudent to conduct a thorough pre-operative and peri-operative genital examination, such as in our case of classical seminoma, to modify surgical technique if malignancy is suspected. In the classical seminoma case presented above, minimal technical modifications were needed due to scrotectomy performed prior to testis removal. However, in cases where scrotal skin may not be removed prior to testis removal, an abnormal testicular exam should prompt consideration of a radical inguinal orchiectomy approach as one would normally use for suspected testicular malignancy.
In the case of the transgender woman with NSGCT, she describes the lack of affirmation received by future clinical encounters as her diagnoses of testicular cancer automates a view by providers that she identifies as male [22]. Additionally, higher-stage seminomas and NSGCTs may also be much more treatment intensive as many are handled with additional oncologic surgery, which may compound the emotional trauma of non-gendered tumors in transgendered patients. More research is needed to investigate how providers can more effectively provide affirming care in cases of gender non-congruent malignancies in TGD patients.
Conclusion
Testicular malignancy may be found incidentally when TGD patients undergo gGAS. Thus, special attention is required to identify suspicious exam findings, so surgical approach may be appropriately adjusted. Careful histological examination of specimens is also warranted to ensure that subclinical disease is appropriately diagnosed, treated, and surveyed. Finally, there is a significant paucity of literature surrounding TGD patient experiences with an incidence of testicular malignancies. It is crucial to continue to investigate how to provide affirming care when navigating discussions of genitalia and management of gender non-congruent malignancies with TGD patients.
REFERENCES
1.
Coleman E, Radix AE, Bouman WP, et al. Standards of care for the health of transgender and gender diverse people, version 8. Int J Transgend Health 2022;23(Suppl 1):S1–259. [CrossRef]
[Pubmed]

2.
van der Sluis WB, Schäfer T, Nijhuis THJ, Bouman MB. Genital gender-affirming surgery for transgender women. Best Pract Res Clin Obstet Gynaecol 2023;86:102297. [CrossRef]
[Pubmed]

3.
Hana T, Raveendran L, Grober E, Potter E, Blodgett N, Krakowsky Y. Initial clinical experience with simple orchiectomy procedures in the context of transition-related surgeries. Int J Transgend Health 2020;21(4):403–9. [CrossRef]
[Pubmed]

4.
Lamichhane A, Mukkamalla SKR. Seminoma. In: StatPearls. Treasure Island (FL): StatPearls Publishing; 2023.
[Pubmed]

5.
Yohannan B, Omo-Ogboi A, Kachira JJ, Jafri SH. Metastatic seminoma presenting as neck and axillary lymphadenopathy in an elderly man. Proc (Bayl Univ Med Cent) 2023;36(3):395–7. [CrossRef]
[Pubmed]

6.
Mohamed YG, Salad NM, Elmia AM, Ali AM. Intraabdominal mass with empty scrotum in adult male revealed as testicular seminoma: A case report. Radiol Case Rep 2022;17(9):3308–11. [CrossRef]
[Pubmed]

7.
Nauman M, Leslie SW. Nonseminomatous Testicular Tumors. In: StatPearls. Treasure Island (FL): StatPearls Publishing; 2023.
[Pubmed]

8.
9.
10.
Malik M, Cooney EE, Brevelle JM, Poteat T. Tucking practices and attributed health effects in transfeminine individuals. Transgender Health 2022. [CrossRef]

11.
Bosland MC. Hormonal factors in carcinogenesis of the prostate and testis in humans and in animal models. Prog Clin Biol Res 1996;394:309–52.
[Pubmed]

12.
Kaushik A, Bhartiya D. Testicular cancer in mice: Interplay between stem cells and endocrine insults. Stem Cell Res Ther 2022;13(1):243. [CrossRef]
[Pubmed]

13.
Giannandrea F, Paoli D, Figà-Talamanca I, Lombardo F, Lenzi A, Gandini L. Effect of endogenous and exogenous hormones on testicular cancer: The epidemiological evidence. Int J Dev Biol 2013;57(2–4):255–63. [CrossRef]
[Pubmed]

14.
Kent MA, Winoker JS, Grotas AB. Effects of feminizing hormones on sperm production and malignant changes: Microscopic examination of post orchiectomy specimens in transwomen. Urology 2018;121:93–6. [CrossRef]
[Pubmed]

15.
Cornejo KM, Oliva E, Crotty R, et al. Clinicopathologic features and proposed grossing protocol of orchiectomy specimens performed for gender affirmation surgery. Hum Pathol 2022;127:21–7.
[Pubmed]

16.
Matoso A, Khandakar B, Yuan S, et al. Spectrum of findings in orchiectomy specimens of persons undergoing gender confirmation surgery. Hum Pathol 2018;76:91–9. [CrossRef]
[Pubmed]

17.
Nash R, Ward KC, Jemal A, Sandberg DE, Tangpricha V, Goodman M. Frequency and distribution of primary site among gender minority cancer patients: An analysis of U.S. national surveillance data. Cancer Epidemiol 2018;54:1–6. [CrossRef]
[Pubmed]

18.
de Nie I, Wiepjes CM, de Blok CJM, et al. Incidence of testicular cancer in trans women using gender-affirming hormonal treatment: A nationwide cohort study. BJU Int 2022;129(4):491–7. [CrossRef]
[Pubmed]

19.
Kvach EJ, Hyer JS, Carey JC, Bowers M. Testicular seminoma in a transgender woman: A case report. LGBT Health 2019;6(1):40–2. [CrossRef]
[Pubmed]

20.
Fine N, Abbott T, Wintner A. Testicular mixed germ cell tumor in a transgender woman. Urol Case Rep 2021;40:101861. [CrossRef]
[Pubmed]

21.
Kobori Y, Suzuki K, Iwahata T, et al. Mature testicular teratoma with positive estrogen receptor beta expression in a transgendered individual on cross-sex hormonal therapy: A case report. LGBT Health 2015;2(1):81–3. [CrossRef]
[Pubmed]

22.
Elshimy G, Tran K, Harman SM, Correa R. Unmasked testicular seminoma during use of hormonal transgender woman therapy: A hidden hCG-secreting tumor. J Endocr Soc 2020;4(7):bvaa074. [CrossRef]
[Pubmed]

SUPPORTING INFORMATION
Acknowledgments
We would like to gratefully acknowledge Ana Lucia Ruano, MD for her assistance in obtaining histological slides for this case series.
Author ContributionsTelisha Tausinga - Conception of the work, Design of the work, Acquisition of data, Analysis of data, Drafting the work, Revising the work critically for important intellectual content, Final approval of the version to be published, Agree to be accountable for all aspects of the work in ensuring that questions related to the accuracy or integrity of any part of the work are appropriately investigated and resolved.
Liem Snyder - Conception of the work, Design of the work, Acquisition of data, Analysis of data, Revising the work critically for important intellectual content, Final approval of the version to be published, Agree to be accountable for all aspects of the work in ensuring that questions related to the accuracy or integrity of any part of the work are appropriately investigated and resolved.
Jonathon Mahlow - Conception of the work, Design of the work, Analysis of data, Revising the work critically for important intellectual content, Final approval of the version to be published, Agree to be accountable for all aspects of the work in ensuring that questions related to the accuracy or integrity of any part of the work are appropriately investigated and resolved.
Cori Agarwal - Conception of the work, Design of the work, Acquisition of data, Analysis of data, Drafting the work, Revising the work critically for important intellectual content, Final approval of the version to be published, Agree to be accountable for all aspects of the work in ensuring that questions related to the accuracy or integrity of any part of the work are appropriately investigated and resolved.
James M Hotaling - Conception of the work, Design of the work, Acquisition of data, Analysis of data, Drafting the work, Revising the work critically for important intellectual content, Final approval of the version to be published, Agree to be accountable for all aspects of the work in ensuring that questions related to the accuracy or integrity of any part of the work are appropriately investigated and resolved.
Benjamin J McCormick - Conception of the work, Design of the work, Analysis of data, Drafting the work, Revising the work critically for important intellectual content, Final approval of the version to be published, Agree to be accountable for all aspects of the work in ensuring that questions related to the accuracy or integrity of any part of the work are appropriately investigated and resolved.
Guaranter of SubmissionThe corresponding author is the guarantor of submission.
Source of SupportNone
Consent StatementWritten informed consent was obtained from the patient for publication of this article.
Data AvailabilityAll relevant data are within the paper and its Supporting Information files.
Conflict of InterestAuthors declare no conflict of interest.
Copyright© 2023 Telisha Tausinga et al. This article is distributed under the terms of Creative Commons Attribution License which permits unrestricted use, distribution and reproduction in any medium provided the original author(s) and original publisher are properly credited. Please see the copyright policy on the journal website for more information.